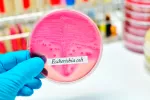
El cinc puede atenuar la virulencia de la bacteria 'E. coli' Cultivo de la bacteria 'E. coli' en el laboratorio

El chocolate negro reduce el estrés y la inflamación

El chocolate oscuro tiene la capacidad de regular las múltiples vías de señalización intracelular.
27/04/2018
El chocolate negro es un alimento rico en flavonoides que se había asociado a la mejora de la memoria. Ahora apuntan que también podría ser positivo para mejorar los niveles de estrés, el estado de ánimo, la inflamación y el sistema inmune. Son dos los estudios que han demostrado estos efectos del cacao, ambos han sido presentados en la reunión anual Experimental Biology 2018 (EE.UU.) y son las primeras pruebas en humanos que valoran los efectos del consumo de chocolate en las funciones cerebrales y cognitivas.
Al parecer, según han expuesto, la finalidad de los investigadores al realizar ambos estudios era conocer cómo el chocolate que tiene una composición de al menos un 70% de cacao y un 30% de azúcar de caña orgánica tiene un impacto en la expresión de los genes de las células dendríticas –propias del sistema inmunitario– y en las citoquinas pro y antiinflamatorias –encargadas de las conexiones entre células–.
Cuanta mayor es la concentración de cacao del chocolate más efectos positivos puede tener sobre la salud mental
Lo que descubrieron fue que el chocolate oscuro tiene la capacidad de regular las múltiples vías de señalización intracelular que están implicadas en la puesta en marcha de las células T, es decir, en la respuesta del sistema inmune celular y los genes que están implicados en la señalización neuronal y la percepción de los sentidos.
Basta con 48 g de chocolate con un 70% de concentración de cacao
Las pruebas de los estudios se realizaron tomando 48 g de chocolate al 70% de cacao y se analizaron las respuestas mediante un encefalograma a los 30 minutos y a los 120 minutos. Los resultados demostraron que este alimento mejoró, tanto a corto como a largo plazo, la neuroplasticidad, el procedimiento cognitivo, la sincronización neural, la memoria y el aprendizaje de los participantes.
Según Lee S. Berk, el investigador principal del estudio y miembro de la Universidad de Loma Linda (California), una dosis tan pequeña como una barra de pequeño tamaño de chocolate negro tiene grandes beneficios para la salud mental de las personas. Además, el estudio ha demostrado que cuanta mayor es la concentración de cacao más efectos positivos tiene, por ello anima a que se ingiera este alimento, siempre con moderación, y en la cantidad más alta de amargor posible.
Actualizado: 6 de noviembre de 2022